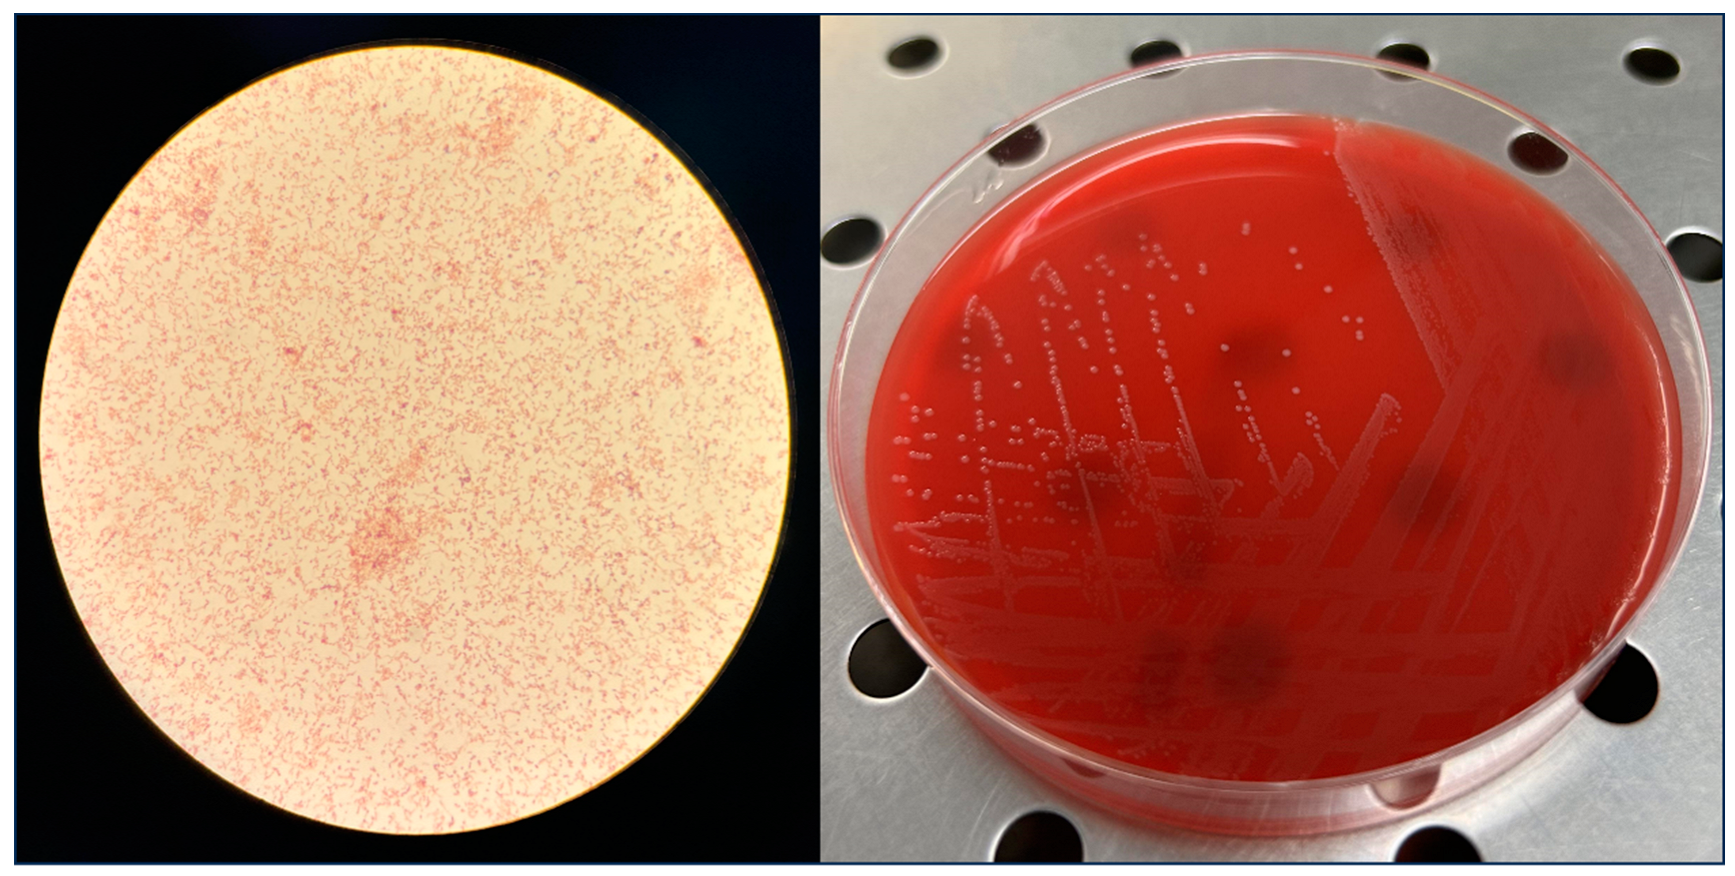
Microorganisms 12 00942 g001

Bloodstream Infection Caused by Erysipelothrix rhusiopathiae in an Immunocompetent Patient
Abstract
1. Introduction
2. Case Description
3. Discussion and Conclusions
Author Contributions
Funding
Institutional Review Board Statement
Informed Consent Statement
Data Availability Statement
Acknowledgments
Conflicts of Interest
References
- Buchanan, R.E. Studies in the Nomenclature and Classification of the Bacteria: V. Subgroups and Genera of the Bacteriaceae. J. Bacteriol. 1918, 3, 27–61. [Google Scholar] [CrossRef] [PubMed]
 - Opriessnig, T.; Coutinho, T.A. Erysipelas. In Diseases of Swine, 11th ed.; Zimmerman, J.J., Karriker, L.A., Ramirez, A., Schwartz, K.J., Stevenson, G.W., Zhang, J., Eds.; John Wiley and Sons, Inc.: Hoboken, NJ, USA, 2019; pp. 835–843. [Google Scholar]
 - Opriessnig, T.; Forde, T.; Shimoji, Y. Erysipelothrix spp.: Past, Present, and Future Directions in Vaccine Research. Front. Vet. Sci. 2020, 7, 174. [Google Scholar] [CrossRef] [PubMed]
 - Reboli, A.C.; Farrar, W.E. Erysipelothrix rhusiopathiae: An occupational pathogen. Clin. Microbiol. Rev. 1989, 2, 354–359. [Google Scholar] [CrossRef] [PubMed]
 - Veraldi, S.; Girgenti, V.; Dassoni, F.; Gianotti, R. Erysipeloid: A review. Clin. Exp. Dermatol. 2009, 34, 859–862. [Google Scholar] [CrossRef] [PubMed]
 - Hill, D.C.; Ghassemian, J.N. Erysipelothrix rhusiopathiae endocarditis: Clinical features of an occupational disease. South. Med. J. 1997, 90, 1147–1148. [Google Scholar] [CrossRef] [PubMed]
 - Connor, M.P.; Green, A.D. Erysipeloid infection in a sheep farmer with coexisting orf. J. Infect. 1995, 30, 161–163. [Google Scholar] [CrossRef] [PubMed]
 - Kiratikanon, S.; Thongwitokomarn, H.; Chaiwarith, R.; Salee, P.; Mahanupab, P.; Jamjanya, S.; Chieosilapatham, P.; Prinyaroj, N.; Tovanabutra, N.; Chiewchanvit, S.; et al. Sweet syndrome as a cutaneous manifestation in a patient with Erysipelothrix rhusiopathiae bacteremia: A case report. IDCases 2021, 24, e01148. [Google Scholar] [CrossRef] [PubMed]
 - Gorby, G.L.; Peacock, J.E., Jr. Erysipelothrix rhusiopathiae endocarditis: Microbiologic, epidemiologic, and clinical features of an occupational disease. Rev. Infect. Dis. 1988, 10, 317–325. [Google Scholar] [CrossRef]
 - Challa, H.R.; Tayade, A.C.; Venkatesh, S.; Nambi, P.S. Erysipelothrix Bacteremia; is Endocarditis a Rule? J. Glob. Infect. Dis. 2022, 15, 31–34. [Google Scholar] [CrossRef] [PubMed]
 - Principe, L.; Bracco, S.; Mauri, C.; Tonolo, S.; Pini, B.; Luzzaro, F. Erysipelothrix Rhusiopathiae Bacteremia without Endocarditis: Rapid Identification from Positive Blood Culture by MALDI-TOF Mass Spectrometry. A Case Report and Literature Review. Infect. Dis. Rep. 2016, 8, 6368. [Google Scholar] [CrossRef] [PubMed]
 - Rostamian, M.; Rahmati, D.; Akya, A. Clinical manifestations, associated diseases, diagnosis, and treatment of human infections caused by Erysipelothrix rhusiopathiae: A systematic review. Germs 2022, 12, 16–31. [Google Scholar] [CrossRef] [PubMed]
 - The European Committee on Antimicrobial Susceptibility Testing. Breakpoint Tables for Interpretation of MICs and Zone Diameters; Version 12.0; EUCAST: Copenhagen, Denmark, 2022. [Google Scholar]
 - Florensa, A.F.; Kaas, R.S.; Clausen, P.T.L.C.; Aytan-Aktug, D.; Aarestrup, F.M. ResFinder—An open online resource for identification of antimicrobial resistance genes in next-generation sequencing data and prediction of phenotypes from genotypes. Microb. Genom. 2022, 8, 000748. [Google Scholar] [CrossRef] [PubMed]
 - Feldgarden, M.; Brover, V.; Gonzalez-Escalona, N.; Frye, J.G.; Haendiges, J.; Haft, D.H.; Hoffmann, M.; Pettengill, J.B.; Prasad, A.B.; Tillman, G.E.; et al. AMRFinderPlus and the Reference Gene Catalog facilitate examination of the genomic links among antimicrobial resistance, stress response, and virulence. Sci. Rep. 2021, 11, 12728. [Google Scholar] [CrossRef]
 - Bikandi, J.; San Millán, R.; Rementeria, A.; Garaizar, J. In silico analysis of complete bacterial genomes: PCR, AFLP-PCR, and endonuclease restriction. Bioinformatics 2004, 20, 798–799. [Google Scholar] [CrossRef] [PubMed]
 - Shiraiwa, K.; Ogawa, Y.; Nishikawa, S.; Eguchi, M.; Shimoji, Y. Identification of serovar 1a, 1b, 2, and 5 strains of Erysipelothrix rhusiopathiae by a conventional gel-based PCR. Vet. Microbiol. 2018, 225, 101–104. [Google Scholar] [CrossRef] [PubMed]
 - Shimoji, Y.; Shiraiwa, K.; Tominaga, H.; Nishikawa, S.; Eguchi, M.; Hikono, H.; Ogawa, Y. Development of a Multiplex PCR-Based Assay for Rapid Serotyping of Erysipelothrix Species. J. Clin. Microbiol. 2020, 58, e00315-20. [Google Scholar] [CrossRef] [PubMed]
 - Batisti Biffignandi, G.; Bellinzona, G.; Petazzoni, G.; Sassera, D.; Zuccotti, G.V.; Bandi, C.; Baldanti, F.; Comandatore, F.; Gaiarsa, S. P-DOR, an easy-to-use pipeline to reconstruct bacterial outbreaks using genomics. Bioinformatics 2023, 39, btad571. [Google Scholar] [CrossRef] [PubMed]
 - Brooke, C.J.; Riley, T.V. Erysipelothrix rhusiopathiae: Bacteriology, epidemiology and clinical manifestations of an occupational pathogen. J. Med. Microbiol. 1999, 48, 789–799. [Google Scholar] [CrossRef] [PubMed]
 - Wood, R.L. Erysipelothrix infection. In Diseases Transmitted from Animals to Man, 6th ed.; Hubbert, W.T., McCulloch, W.F., Schnurrenberger, P.R., Eds.; Thomas: Springfield, IL, USA, 2019; pp. 271–281. [Google Scholar]
 - Selbitz, H.-J.; Truyen, U.; Valentin-Weigand, P. Tiermedizinische Mikrobiologie, Infektions- und Seuchenlehre. 9., Vollständig Überarbeitete Auflage; Thieme Verlag: New York, NY, USA, 2011. [Google Scholar]
 - Zautner, A.E.; Tersteegen, A.; Schiffner, C.J.; Ðilas, M.; Marquardt, P.; Riediger, M.; Delker, A.M.; Mäde, D.; Kaasch, A.J. Human Erysipelothrix rhusiopathiae infection via bath water—Case report and genome announcement. Front. Cell. Infect. Microbiol. 2022, 12, 981477. [Google Scholar] [CrossRef] [PubMed]
 - Fidalgo, S.G.; Longbottom, C.J.; Rjley, T.V. Susceptibility of Erysipelothrix rhusiopathiae to antimicrobial agents and home disinfectants. Pathology 2002, 34, 462–465. [Google Scholar] [CrossRef] [PubMed]
 - Venditti, M.; Gelfusa, V.; Tarasi, A.; Brandimarte, C.; Serra, P. Antimicrobial susceptibilities of Erysipelothrix rhusiopathiae. Antimicrob. Agents Chemother. 1990, 34, 2038–2040. [Google Scholar] [CrossRef]
 - Campbell, D.; Cowan, M. Septicemia and Aortic Valve Endocarditis due to Erysipelothrix rhusiopathiae in a Homeless Man. Case Rep. Infect. Dis. 2013, 2013, 923034. [Google Scholar]

| Strain | PNG (R > 2)  | TZP (R > 16)  | CRO (R > 2)  | IMI (R > 4)  | CIP (R > 0.5)  | MTZ | TET | VAN | CC | EE | D Test | 
|---|---|---|---|---|---|---|---|---|---|---|---|
| PV7573 | 0.125 (S) | 0.064 (S) | 0.064 (S) | 0.006 (S) | 0.032 (S) | >256 (-)  | 0.5  (-)  | 32  (-)  | 0.064 (-)  | 0.025 (-) | Negative | 
Disclaimer/Publisher’s Note: The statements, opinions and data contained in all publications are solely those of the individual author(s) and contributor(s) and not of MDPI and/or the editor(s). MDPI and/or the editor(s) disclaim responsibility for any injury to people or property resulting from any ideas, methods, instructions or products referred to in the content.  | 
© 2024 by the authors. Licensee MDPI, Basel, Switzerland. This article is an open access article distributed under the terms and conditions of the Creative Commons Attribution (CC BY) license (https://creativecommons.org/licenses/by/4.0/).
Share and Cite
Mileto, I.; Merla, C.; Corbella, M.; Gaiarsa, S.; Kuka, A.; Ghilotti, S.; De Cata, P.; Baldanti, F.; Cambieri, P. Bloodstream Infection Caused by Erysipelothrix rhusiopathiae in an Immunocompetent Patient. Microorganisms 2024, 12, 942. https://doi.org/10.3390/microorganisms12050942
Mileto I, Merla C, Corbella M, Gaiarsa S, Kuka A, Ghilotti S, De Cata P, Baldanti F, Cambieri P. Bloodstream Infection Caused by Erysipelothrix rhusiopathiae in an Immunocompetent Patient. Microorganisms. 2024; 12(5):942. https://doi.org/10.3390/microorganisms12050942
Chicago/Turabian StyleMileto, Irene, Cristina Merla, Marta Corbella, Stefano Gaiarsa, Angela Kuka, Stefania Ghilotti, Pasquale De Cata, Fausto Baldanti, and Patrizia Cambieri. 2024. "Bloodstream Infection Caused by Erysipelothrix rhusiopathiae in an Immunocompetent Patient" Microorganisms 12, no. 5: 942. https://doi.org/10.3390/microorganisms12050942
APA StyleMileto, I., Merla, C., Corbella, M., Gaiarsa, S., Kuka, A., Ghilotti, S., De Cata, P., Baldanti, F., & Cambieri, P. (2024). Bloodstream Infection Caused by Erysipelothrix rhusiopathiae in an Immunocompetent Patient. Microorganisms, 12(5), 942. https://doi.org/10.3390/microorganisms12050942
        
